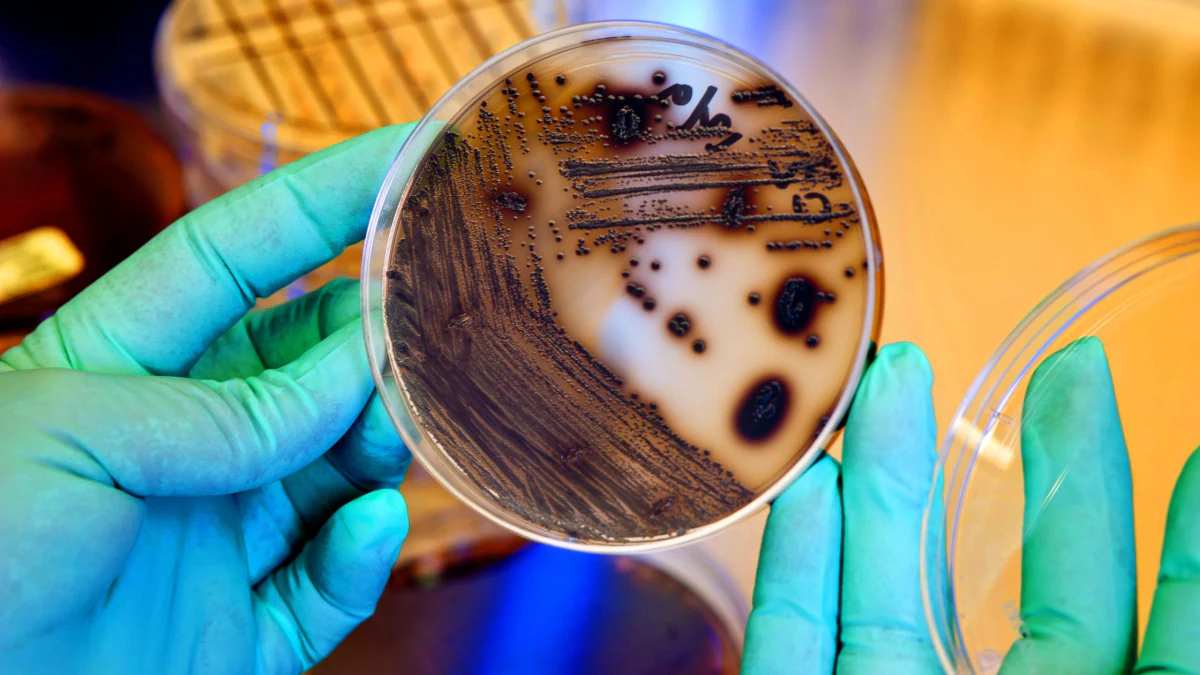
Corynebacterium diphtheriae on Trisdal plate Diphtheria bacteria growing on a Tinsdale plate.

Key points
- CDC has a laboratory focused on innovative research related to pertussis and diphtheria.
- CDC maintains extensive culture collections that span several years and geographical locations.
- Our team can assist health departments and public health laboratories upon request.
Our work
As its name implies, CDC's Pertussis and Diphtheria Laboratory focuses on pertussis- and diphtheria-related pathogens. CDC maintains extensive culture collections that span several years and geographical locations.
Pathogens related to pertussis and diphtheria
- Bordetella pertussis
- B. bronchiseptica
- B. holmesii
- B. bronchiseptica
- Corynebacterium diphtheriae
- C. pseudotuberculosis
- C. ulcerans
Key activities
Key activities for the Pertussis and Diphtheria Laboratory include:
- Researching new and improved laboratory methods
- Helping U.S. laboratories, including in response to outbreaks
- Building international diagnostic capacity
Innovative laboratory research
CDC's Pertussis and Diphtheria Laboratory works to enhance the diagnosis and surveillance of agents that cause pertussis or diphtheria.
The laboratory does that by researching methods to improve laboratory testing capabilities. Specifically, CDC actively develops, evaluates, implements, and improves molecular and serologic methods, techniques, and strategies.
U.S. laboratory support
Reference laboratory
As a reference laboratory, CDC's Pertussis and Diphtheria Laboratory supports U.S. health departments and public health laboratories with
- Pathogen isolation and identification from clinical specimens
- Outbreak response
- Priority public health concerns
Pathogen isolation and identification
Related to Bordetella and Corynebacterium, the laboratory can offer advice concerning laboratory procedures dealing with
- Isolation and identification of organisms from clinical specimens
- Detection of organisms by polymerase chain reaction
- Testing serum for immunoglobulin G antibodies to pertussis toxin
- Molecular characterization of organisms by next generation sequencing
U.S. health departments and public health laboratories can request assistance with isolation, identification, and molecular characterization when pertussis or diphtheria is suspected.
Why it's important
Confirming B. pertussis in the laboratory can be difficult. This difficulty contributes to under-reporting of disease. Problematic testing for B. pertussis can compromise
- Prevention programs
- Surveillance activities
- Vaccine effectiveness studies
- Outbreak management
Outbreak response
Health departments can request assistance from CDC during outbreaks. Ask to be put in touch with the Meningitis, Pertussis, & Diphtheria Epidemiology Branch by either
- Calling 1-800-CDC-INFO
- Submitting a request online
The branch will make sure various experts, including laboratorians, are engaged based on the specific needs of each outbreak.
Priority public health concerns
Upon request, the laboratory can test for the presence of diphtheria toxin by the Elek assay for C. diphtheriae and C. ulcerans isolates.
If there's a suspected diphtheria case that requires assistance, call CDC's Emergency Operations Center at 770-488-7100.
International capacity building
CDC actively participates in international capacity building and consultation for both diphtheria and pertussis diagnostics.
Resources
CDC disease sites
Manual for the Surveillance of Vaccine-Preventable Diseases
In addition to providing current surveillance guidelines, the manual also provides information about specimen collection and shipping.